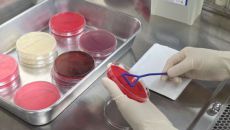

이슈뉴스
-

성남시, 업소 581곳 대상 식품 위생관리 진단평가 실시
C·D·E등급 업소는 재평가·개선 사항 확인 점검 [더팩트ㅣ성남=조수현 기자] 경기 성남시는 식중독 예방을 위해 오는 11일부- 2025.08.08 09:14
- 더팩트
-

완도군, 여성 어업인 건강검진비 전액 지원
완도군은 51세 이상 여성 어업인을 대상으로 특화 건강검진비 전액 지원 사업을 추진한다. 여성 어업인은 근골격계에 부담이 많이- 2025.08.08 09:09
- 메트로신문사
-

[동정] 질병청장, 코로나19 재유행 대비 방역물자 비축 점검
▲ 임승관 질병청장은 7일 코로나19 재유행에 대비해 경기 용인시에 있는 방역물자비축센터 '한컴라이프케어'를 찾아 개인보호구- 2025.08.08 09:06
- 연합뉴스
-

인천시, '2025 APEC 고위관리회의' 식음료 안전관리 총력
식품위생감시원들 새벽부터 '구슬땀' 식중독 예방 위한 지도·교육·홍보 진행 [더팩트ㅣ인천= 김재경 기자] 인천시가 지난달 26- 2025.08.08 09:04
- 더팩트
-
전남동물위생시험소, 폭염 피해 예방 낙농가 사양관리 당부
전라남도동물위생시험소는 연일 계속되는 폭염으로 젖소가 고온 스트레스를 받기 쉬운 상황에서 면역력 저하와 함께 원유 생산량 감소- 2025.08.08 08:58
- 아시아경제
-

강동구 '스마트 통합 해충방제 장치' 도입…해충 유인·살충
(서울=연합뉴스) 정수연 기자 = 서울 강동구(구청장 이수희)는 해충을 매개로 한 감염병에 대응하기 위해 방역체계를 강화했다고- 2025.08.08 08:56
- 연합뉴스
-

청년 '제빵왕' 키운다…영등포구, 베이커리 기능사 아카데미
(서울=연합뉴스) 정수연 기자 = 서울 영등포구(구청장 최호권)가 청년 제과·제빵 자격증 취득반 '청년 베이커리 기능사 양성- 2025.08.08 08:51
- 연합뉴스
-

기아대책·민사고 학생들, 라오스 식수문제 해결 앞장
국제구호개발 NGO(비정부단체) 희망친구 기아대책(회장 최창남)은 민족사관고등학교 '옹달샘' 학생들과 함께 라오스 비엔티엔 지- 2025.08.08 08:40
- 아시아경제
-

전공의 복귀해도 해결과제 첩첩산중… 의정갈등 남은 문제는?
정부와 의료계가 사직 전공의들의 기존 병원 복귀와 초과 정원, 입영 연기 등을 모두 허용하면서 다음 달 시작되는 하반기 수련에- 2025.08.08 08:31
- 아시아경제
-

재난 트라우마 쌓이는데···정부 예산은 '뒷걸음'
지난달 16일부터 쏟아진 폭우로 경기 가평군 조종면에 거주하는 70대 A 씨의 집이 물에 잠겼다. 다행히 인명 피해는 없었지만- 2025.08.08 07:00
- 서울경제
-

"킴카다시안은 비타민, 우리는 지방줄기세포"...K-웰니스, 현주소는?
[이데일리 이순용 기자] 최근 미국 셀럽들 사이에서 이른바 ‘링거 주사’가 하나의 웰니스 루틴으로 자리 잡고 있다. 킴 카다시- 2025.08.08 06:52
- 이데일리
-

[전문의 칼럼] 어린이는 왜 중이염에 잘 걸리나?
[조명구 엠블병원 병원장] 귀는 외이, 중이, 내이로 구분된다. 중이염은 중이강내에 고름이 차면서 염증이 생기는 것을 말하며,- 2025.08.08 06:42
- 이데일리
-

“노동 사건 6개 지방노동청서 따로 수사… 환경부·식약처처럼 본부 전담 조직 필요” [심층기획-갈 길 먼 근로감독관제]
이재명정부가 ‘노동경찰’ 격인 근로감독관을 늘리고 근로감독권 지방자치단체 이양까지 추진 중인 가운데 국회에선 단순한 양적 확대- 2025.08.08 06:00
- 세계일보
-

Z세대 '교내 스마트폰 금지'…"정부가 직접 개입해야"
[편집자 주] 이데일리는 대한민국 2000년생 청년들의 현주소를 파악하기 위한 특별기획을 마련했습니다. 2000년생들이 직면한- 2025.08.08 05:00
- 이데일리
-

여수 숙박·관광시설 먹칠…'친절 실천 대회' 열려
최근 여수시 관내 음식·숙박업소의 불친절 및 비위생 문제가 잇따라 보도되며 관광 이미지 훼손 우려로 남해안 중추 관광도시 위상- 2025.08.07 18:57
- 아시아경제
-

전공의 '입영 연기' 특례 수용한 정부···"의사불패 재확인"
특혜 반대 여론에도 전공의 '입영 연기·자리 보장' 요구 수용 집단행동 재발 방지 조치 전무...환자들 "집단행동 재발 가능"- 2025.08.07 18:38
- 더팩트
-

급식노동자 14명 폐암 산재 사망…"환기 개선·인력 충원 시급"
2021년부터 4년간 208명 산재 신청, 175명 인정 폐암 확진 당사자 "밥으로 진 빼니 남은 건 병뿐" [더팩트ㅣ정인지- 2025.08.07 18:02
- 더팩트
-

여수시, 음식·숙박업소 친절 실천 자정 결의대회 개최
최근 음식점과 숙박업소의 '불친절·비위생' 등으로 구설에 오른 전남 여수시가 7일 '친절 실천 자정 결의대회'를 개최했다. 이- 2025.08.07 17:56
- 아시아경제
-

상담 수요 늘어나는데 예산은 뒷걸음··· 외면받는 '재난 심리'
지난달 16일부터 쏟아진 폭우로 경기 가평군 조종면에 거주하는 70대 A 씨의 집이 물에 잠겼다. 다행히 인명 피해는 없었지만- 2025.08.07 17:53
- 서울경제
-

“죽음의 학교급식실 폐암 문제 해결하라”…14번째 급식노동자 폐암 사망 [현장 화보]
민주노총 서비스연맹 전국학교비정규직노동조합 소속 조합원과 급식노동자들이 7일 서울 종로구 국정기획위원회 앞에서 기자회견을 열고- 2025.08.07 17:46
- 경향신문
-

1년 반 만에 '복귀' 길 열린 사직 전공의들…의정갈등 마침표 찍나
정부와 의료계가 사직 전공의들의 수련 복귀를 위한 세부 조건에 합의하면서 상당수 사직 전공의들이 다음 달 하반기 수련을 재개할- 2025.08.07 17:22
- 아시아경제
-

[오늘의 운세] 8월 8일 금요일 (음력(윤) 6월 15일 己酉)
36년생 상대 탓하기 전에 나 자신부터 점검. 48년생 열정만 있으면 꿈 이루어진다. 60년생 윗사람의 태도가 아랫사람의 태도- 2025.08.07 17:00
- 조선일보
-

세스코 ‘60살 이상 고용승계 불가’ 방침에 인천공항 방역 노동자들 반발
“코로나19 펜데믹때 방역 최전선에서 나라를 지킨다는 자부심으로 일했어요. 그런 자부심도 배신감으로 바뀌네요.” 한마음인천공항- 2025.08.07 16:33
- 한겨레
-

경기도 한우 고급육 평가대회, 안성 곽근원 농가 '대상'
경기도는 7일 도드람안성축산물공판장에서 열린 '제7회 경기 한우 고급육 평가대회'에서 안성시 곽근원씨 농가의 한우를 올해 경기- 2025.08.07 16:27
- 아시아경제
-

[철원소식] 여름철 말라리아 예방 수칙 준수 당부
(철원=연합뉴스) ▲ 여름철 말라리아 예방 수칙 준수 당부 = 강원 철원군은 여름철 야외 활동이 잦은 주민들에게 말라리아 예방- 2025.08.07 16:24
- 연합뉴스

